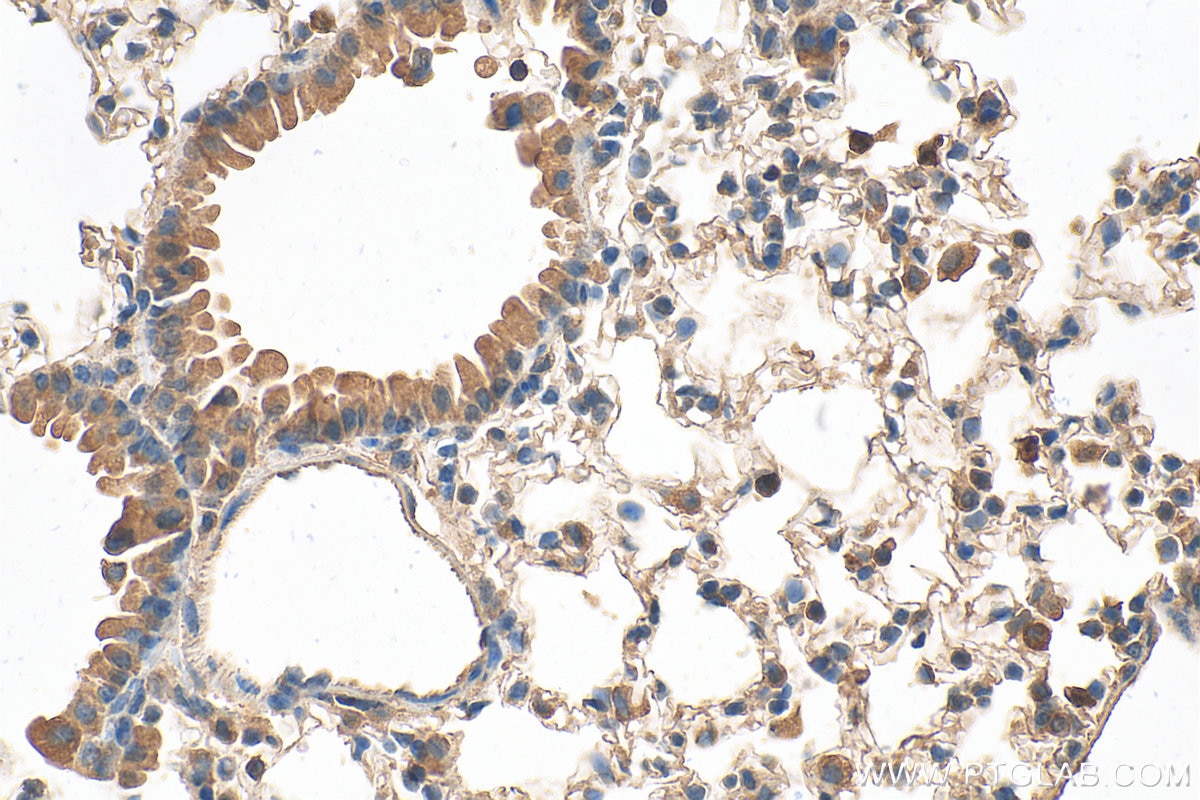
Immunohistochemical analysis of paraffin-embedded mouse lung tissue slide using 24899-1-AP (LRP5 antibody) at dilution of 1:1000 (under 40x lens). Heat mediated antigen retrieval with Tris-EDTA buffer (pH 9.0). Immunohistochemistry (IHC) staining of mouse lung tissue using LRP5 Polyclonal antibody (24899-1-AP)

Tested Applications
| Positive WB detected in | HeLa cells |
| Positive IHC detected in | mouse lung tissue, human hepatocirrhosis tissue, human liver cancer tissue Note: suggested antigen retrieval with TE buffer pH 9.0; (*) Alternatively, antigen retrieval may be performed with citrate buffer pH 6.0 |
| Positive IF/ICC detected in | HeLa cells |
Recommended dilution
| Application | Dilution |
|---|---|
| Western Blot (WB) | WB : 1:500-1:1000 |
| Immunohistochemistry (IHC) | IHC : 1:50-1:2000 |
| Immunofluorescence (IF)/ICC | IF/ICC : 1:50-1:500 |
| It is recommended that this reagent should be titrated in each testing system to obtain optimal results. | |
| Sample-dependent, Check data in validation data gallery. | |
Published Applications
| KD/KO | See 1 publications below |
| WB | See 11 publications below |
| IHC | See 5 publications below |
| IF | See 4 publications below |
| IP | See 1 publications below |
Product Information
24899-1-AP targets LRP5 in WB, IHC, IF/ICC, IP, ELISA applications and shows reactivity with human, mouse samples.
| Tested Reactivity | human, mouse |
| Cited Reactivity | human, mouse, rat |
| Host / Isotype | Rabbit / IgG |
| Class | Polyclonal |
| Type | Antibody |
| Immunogen |
CatNo: Ag19034 Product name: Recombinant human LRP5 protein Source: e coli.-derived, PET28a Tag: 6*His Domain: 1332-1397 aa of BC150595 Sequence: CDAICLPNQFRCASGQCVLIKQQCDSFPDCIDGSDELMCEITKPPSDDSPAHSSAIGPVIGIILSL Predict reactive species |
| Full Name | low density lipoprotein receptor-related protein 5 |
| Calculated Molecular Weight | 1615 aa, 179 kDa |
| Observed Molecular Weight | 180-200 kDa |
| GenBank Accession Number | BC150595 |
| Gene Symbol | LRP5 |
| Gene ID (NCBI) | 4041 |
| RRID | AB_2879786 |
| Conjugate | Unconjugated |
| Form | Liquid |
| Purification Method | Antigen affinity purification |
| UNIPROT ID | O75197 |
| Storage Buffer | PBS with 0.02% sodium azide and 50% glycerol, pH 7.3. |
| Storage Conditions | Store at -20°C. Stable for one year after shipment. Aliquoting is unnecessary for -20oC storage. 20ul sizes contain 0.1% BSA. |
Background Information
Low-density lipoprotein receptor-related protein 5 (LRP5) is a single-pass type I membrane protein with EGF-like and LDLR domains in the extracellular domain. LRP5 and LRP6 act as coreceptors with Frizzled for Wnt. The complex of Wnt-Fzd-LRP5-LRP6 triggers beta-catenin signaling through inducing aggregation of receptor-ligand complexes into ribosome-sized signalsomes. LRP5 plays a key role in skeletal homeostasis and many bone density related diseases are caused by mutations in LRP5 gene.
Protocols
| Product Specific Protocols | |
|---|---|
| IF protocol for LRP5 antibody 24899-1-AP | Download protocol |
| IHC protocol for LRP5 antibody 24899-1-AP | Download protocol |
| WB protocol for LRP5 antibody 24899-1-AP | Download protocol |
| Standard Protocols | |
|---|---|
| Click here to view our Standard Protocols |
Publications
| Species | Application | Title |
|---|---|---|
Stem Cell Res Ther LINC01119 negatively regulates osteogenic differentiation of mesenchymal stem cells via the Wnt pathway by targeting FZD4. | ||
Front Pharmacol Sini San Inhibits Chronic Psychological Stress-Induced Breast Cancer Stemness by Suppressing Cortisol-Mediated GRP78 Activation. | ||
Calcif Tissue Int Coenzyme Q10 Protects Against Hyperlipidemia-Induced Osteoporosis by Improving Mitochondrial Function via Modulating miR-130b-3p/PGC-1α Pathway | ||
Pharm Biol Yiguanjian decoction inhibits macrophage M1 polarization and attenuates hepatic fibrosis induced by CCl4/2-AAF. | ||
Chin J Integr Med Babao Dan () Alleviates 5-Fluorouracil-Induced Intestinal Damage via Wnt/β-Catenin Pathway. | ||
J Orthop Sci Wnt signaling pathway correlates with ossification of the spinal ligament: A microRNA array and immunohistochemical study. |